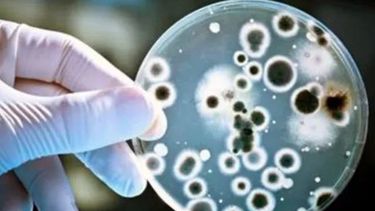
Aún no detectan en San Juan la bacteria que mató a 16 personas, pero piden prevención

Leer al lado de la estufa
En vacaciones aumentó la venta de libros en San Juan: los más elegidos y los precios
A pesar de que los libros registraron un 20% de aumento, en los últimos días las ventas casi se duplicaron.
Por Daiana Kaziura